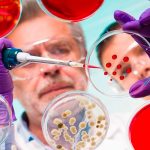
microbios buenos

Etiqueta: enfermedades infecciosas
Cuba confirma 32 nuevos casos de coronavirus, para un acumulado de 320
El director nacional de epidemiología del Ministerio de Salud Pública (Minsap) en Cuba, Francisco Durán, dio a conocer este domingo una actualización de la...
421 mil personas fallecen cada año por tuberculosis en la India
Nueva Delhi, 4 abr (Prensa Latina) La enfermedad de la tuberculosis mata cada año a 421 mil indios y le cuesta al país surasiático...
La «Enfermedad zombie» provoca alerta en Estados Unidos
Pérdida de peso, deterioro físico y agresividad, esos son algunos de lo síntomas de la "enfermedad zombie" que afecta a los venados y tiene...
La OMS cree que hay millones de casos de sarampión que no se reportan
Ginebra, 14 feb (EFE).- Los expertos de la Organización Mundial de la Salud (OMS) estiman que actualmente hay “millones de casos de sarampión” que...
El «Arca de Noe» hecha de microbios humanos será la cura contra la crisis...
La creación de una reserva mundial de microbioma humano, un "Arca de Noé" de microbios buenos, puede ser el antídoto ante la crisis global...
¿cómo evitar la propagación de enfermedades infecciosas?
Según la Organización Mundial de la Salud, se llaman enfermedades infecciosas a todas aquellas causadas por microorganismos patógenos como las bacterias, los virus, los...